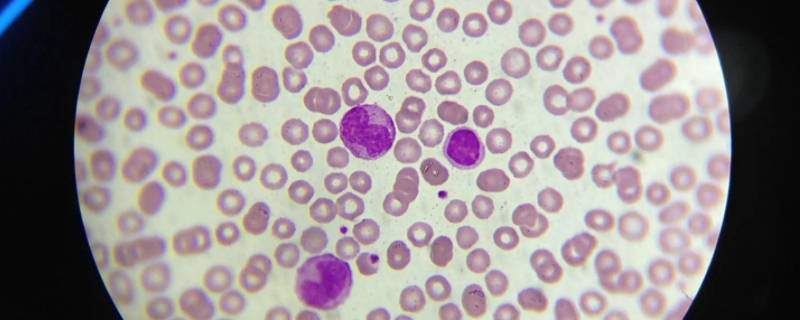
约35亿年前地球上出现了什么细胞（35亿年前的细胞）

文章资讯
父母对孩子的简短寄语 父母对孩子的简短寄语幼儿园小班
1、人生就像咀嚼橄榄,总是先苦而后甜。2、要知道:“说话语气比内容重要得多”。3、健康是第一位的。人倒了,一切就都没了。4
精神文明建设的四有内容是什么(精神文明建设四德内容)
最佳答案有理想、有道德、有文化、有纪律。党的十九大以来,精神文明建设工作以总书记重要讲话精神为指引,把培养时代新人作为着眼点,培育和践行社会主义核心价值观,引导全社会树立文明观念、提高文明程度、形成文明风尚,不断推动人民在理想信念、价值理念、道德观念上紧紧团结在一起。
女人的格局大气语录(形容女人的格局大气语录)
1、一个有格局的女人,永远清楚自己为什么而活,从来都是自己掌握生活,而不是被生活掌握。2、把快乐建立在别人快乐之上的人,一定是个宽容
真正的朋友经典语录 真正的朋友经典语录英文
1、朋友之间不言谢,遇见,就是幸福。2、真正的朋友,无须想起,因为从未忘记。3、真正的朋友,了解你比你自己还要多一点。4、我的朋友虽然少
高血压能吃蜂蜜吗 高血压能吃蜂蜜吗每天喝多少合适
在如今的生活中,高血压患者基本上随处可见,对于高血压的日常饮食也是很多人关注的一个热点问题,接下来就为大家科普一下高血压能不能吃蜂蜜。
脑梗塞中药治疗方法 脑梗塞中药治疗方法
脑梗塞一直以来都是老年人当中最危险的疾病之一,针对这种情况,需要加以治疗。那么对于脑梗塞中药治疗方法,就为大家讲解一下。
冠心病药物治疗效果还行,需要做支架吗
冠心病是属于较为繁琐的疾病,需要进过长期的治疗以及日常的细心维护,那么就给大家分析一下冠心病药物治疗效果还行的情况下,需不需要做支架。
什么是痔疮的症状(什么是痔疮的症状图片)
痔疮这一疾病,一直以来都是困扰着众多男性的一种常见疾病之一,很多男性都是较为害怕患这一疾病的,那么就来了解一下痔疮的症状有哪些。
景点游玩朋友圈怎么写(景点游玩朋友圈怎么写说说)
最佳答案1、找一个大风去见你把我吹进你怀里。2、周末出去走走看看花吹吹风见一见生活圈之外的美好。3、做一个世界的水手,游遍每一个港口。4、任何事情只要熬过那段崩溃的时间,都会过去的。5、一个人的旅行在路上遇见最真实的自己。6、感情摧毁不了一个人的向死而生才能所向披靡。
腰肌劳损治疗方法有什么(腰肌劳损治疗方法有什么特点)
腰肌劳损对于中老年人来说,是很煎熬的一种疾病,很多人都对腰肌劳损该如何治疗不太熟悉,接下来就来说说腰肌劳损治疗方法。
胰腺癌晚期能活多久 胰腺癌晚期能活多久一般
患癌症对于人们来说,是一个绝望的消息,特别是胰腺癌症晚期,更是不治之症,一般胰腺癌晚期的人能活多久也一直是人们想要了解的问题,那么下面就为大家分析。
三潭印月打一数字(三潭印月影打一个数字)
三潭印月打一数字为3,因为三潭解数字和3相同,故打一数字是3。数字分好几种,阿拉伯数字是最普遍的一种。阿拉伯数字并不是阿拉伯人发明的
什么颜色加什么颜色等于红色橡皮泥(什么颜色和什么颜色的橡皮泥)
最佳答案红色不能用其他颜色混合调出来,因为红色属于三原色之一。三原色是色彩中不能再分解的三种基本颜色,通常说的三原色,即品红、黄、青。三原色可以混合出所有的颜色,同时相加为黑色,黑白灰属于无色系,因此红色作为颜料三原色之一,不能由其他二色混合产生,不论用什么方法、什么材质的颜料,也无法通过其它颜色来调出红色。
凉露惊秋是什么意思(清秋风露是什么意思)
凉露惊秋是指秋天带来了凉意。秋天的风吹来,感到一阵凉爽,摸到凉意的露水,突然感到秋天到了,晶莹的露珠使人产生寒冷的感觉。凉露是指凉
10条朋友之间的友谊说说 朋友之间的友谊说说 朋友的话
1、想和你一起变成可爱的老太太,在养老院聊聊帅老头。2、你不善言辞总口吐芬芳,只有我明白你的温柔。3、我们可以吵架,但不能影响关系,无
脂溢性皮炎是怎么引起的 脂溢性皮炎是怎么引起的?
脂溢性皮炎对于很多患者来说,都是较为困扰的,特别是女性,影响形象外观,影响日常生活以及工作。对于脂溢性皮炎,下面就为大家科普一下引起原因。
多发性脑梗塞宜吃些什么 多发性脑梗塞宜吃些什么药
多发性脑梗塞宜吃些什么?提起这个还是有点遗憾和悲伤,小编的爷爷就是因为脑梗塞导致中风偏瘫,最后没有两年就去世了,所以各位朋友还是应该多关注下老人的身体健康,这里小编就从日常生活中常见的食物介绍多发性脑梗塞宜吃些什么?
脂溢性皮炎是怎么引起的(头皮脂溢性皮炎是怎么引起的)
脂溢性皮炎对于很多患者来说,都是较为困扰的,特别是女性,影响形象外观,影响日常生活以及工作。对于脂溢性皮炎,下面就为大家科普一下引起原因。
电脑怎么联网连接wifi密码 电脑怎么联网连接wifi
演示机型:华为MateBook X系统版本:win10 电脑怎么联网连接wifi密码
约35亿年前地球上出现了什么细胞(35亿年前的细胞)
约35亿年前地球上出现了原核细胞,大约在12~14亿年前才出现真核细胞。原核细胞是组成原核生物的细胞。这类细胞主要特征是没有以核膜为
手机酷狗怎么往u盘上传歌(手机酷狗怎么往u盘上传歌为什么显示出现异常无法导入)
演示机型:华为P50系统版本:HarmonyOS 2APP版本:酷狗音乐11.1.4 手机
儿童口腔溃疡的原因(儿童口腔溃疡的原因小儿大便)
儿童口腔溃疡的原因?最近我感觉一直就没离开过口腔溃疡,因为这几天一直都面对口腔溃疡患者朋友提出的各种问题,只是问题越来越具体,一开始只是问口腔出血,后来就是口腔长血泡,现在儿童口腔溃疡的原因。
小孩便秘怎么调理
因为孩子还小,自然会出现很多问题,小儿便秘就是我们最常见的一种疾病,再加上孩子可能不会很好的表达出来,今天就给大家科普关于小儿便秘的知识。
qq怎么在其他应用上小屏显示 苹果qq怎么在其他应用上小屏显示
演示机型:Iphone 13&&华为P50&&小米12系统版本:iOS 15.4&&HarmonyOS 2&&MIUI 13APP版本:QQ v8.8.68.629
磨牙怎么根治 磨牙怎么根治最有效
人在进入深度睡眠的时候会出现很多奇怪的现象,有人打呼噜,也有人会有磨牙的情况,但是很多人都不知道磨牙怎么治疗,今天,就以此为题,为大家介绍一些治疗磨牙的方法。
落日晚风的尽头是什么意思 落日晚风暗示什么
落日晚风的尽头意思是:落日余晖,晚风轻拂,再美的景色都有尽头。《晚风》是伍佰的歌曲,唱的是两个曾经相爱的人又相遇了,两人都很想再回到
十号风球打一生肖
十号风球没有指代的生肖,它是香港著名歌手张国荣2002年演唱的歌曲,收录于专辑《Cross Over》中。张国荣(1956年9月12日-2003年4月1日),出
景琰这个名字寓意 景琰这个名字寓意创意名字
最佳答案寓意温润柔和、德高望重、令人敬仰。景的本意是指亮光或日光,后来引申为大或仰慕之意,经常在人名中出现。琰指一种美玉,是一种上部分呈现尖端的玉圭,是帝王与诸侯们在举行典礼时使用的礼器,用到人名中形容人温润如玉却有着独特的棱角,有较强的个人魅力。
治疗糜烂性胃炎的中成药 治疗糜烂性胃炎的中成药有几种
糜烂性胃炎是比较严重的一种疾病,患者平时一定要注意饮食。有一些比较好的治疗糜烂性胃炎的中成药,我给大家推荐一下,如果有需要的朋友可以了解一下。
焦虑症能彻底治好吗 惊恐焦虑症能彻底治好吗
人在各种年龄段都会患有一定的焦虑症,会使得患者自己和患者身边的朋友很头疼,于是问题就来了,焦虑症会不会这样一直下去,有没有治好的可能,不要着急,接着往下看。